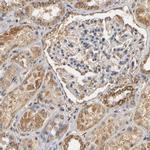
PKN1 Antibody in Immunohistochemistry (IHC)

Search
Invitrogen
PKN1 Polyclonal Antibody
{{$productOrderCtrl.translations['antibody.pdp.commerceCard.promotion.promotions']}}
{{$productOrderCtrl.translations['antibody.pdp.commerceCard.promotion.viewpromo']}}
{{$productOrderCtrl.translations['antibody.pdp.commerceCard.promotion.promocode']}}: {{promo.promoCode}} {{promo.promoTitle}} {{promo.promoDescription}}. {{$productOrderCtrl.translations['antibody.pdp.commerceCard.promotion.learnmore']}}
产品信息
PA5-52036
种属反应
宿主/亚型
分类
类型
抗原
偶联物
形式
浓度
规格
纯化类型
保存液
内含物
保存条件
运输条件
RRID
产品详细信息
Immunogen sequence: QKLGLLREAL ERRLGELPAD HPKGRLLREE LAAASSAAFS TRLAGPFPAT HYSTLCKPAP LTGTLEVRVV GCRDLPETIP WNPTPSMGGP GTPDSRPPFL SRPARGLYSR SGSLSGRSSL KAEAENTSEV S
Highest antigen sequence identity to the following orthologs: Mouse - 85%, Rat - 86%.
靶标信息
PKN1 (PRK1) belongs to the protein kinase C superfamily. This kinase is activated by the Rho family of small G proteins and may mediate the Rho-dependent signaling pathway. This kinase can also be activated by phospholipids. The 3-phosphoinositide dependent protein kinase-1 (PDPK1/PDK1) is reported to phosphorylate this kinase, which may mediate insulin signals to the actin cytoskeleton. The proteolytic activation of this kinase by caspase-3 or related proteases during apoptosis suggests its role in signal transduction related to apoptosis. Alternatively spliced transcript variants encoding distinct isoforms have been observed.
仅用于科研。不用于诊断过程。未经明确授权不得转售。
篇参考文献 (0)
生物信息学
蛋白别名: PAK-1; Protease-activated kinase 1; Protein kinase C-like 1; Protein kinase C-like PKN; protein kinase C-related kinase 1; protein kinase PKN; Protein kinase PKN-alpha; Protein-kinase C-related kinase 1; serine-threonine kinase N; Serine-threonine protein kinase N; serine/threonine kinase 3; serine/threonine protein kinase N; Serine/threonine-protein kinase N1; unnamed protein product
基因别名: DBK; F730027O18Rik; PAK-1; PAK1; PKN; PKN-ALPHA; PKN1; PRK1; PRKCL1; Stk3
UniProt ID: (Human) Q16512, (Rat) Q63433, (Mouse) P70268
Entrez Gene ID: (Human) 5585, (Rat) 29355, (Mouse) 320795